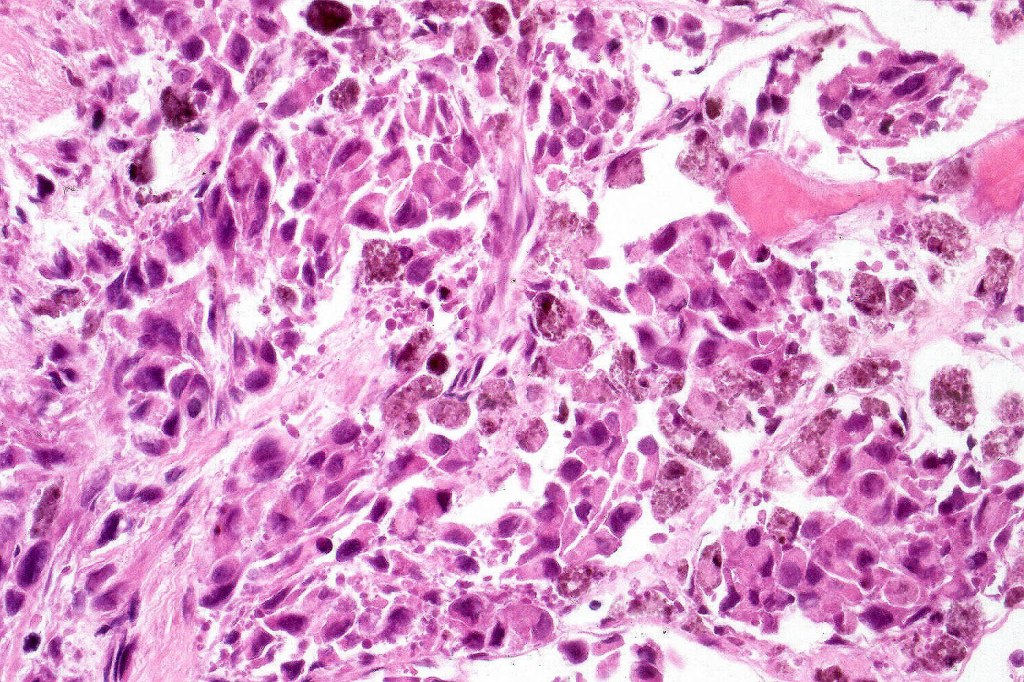
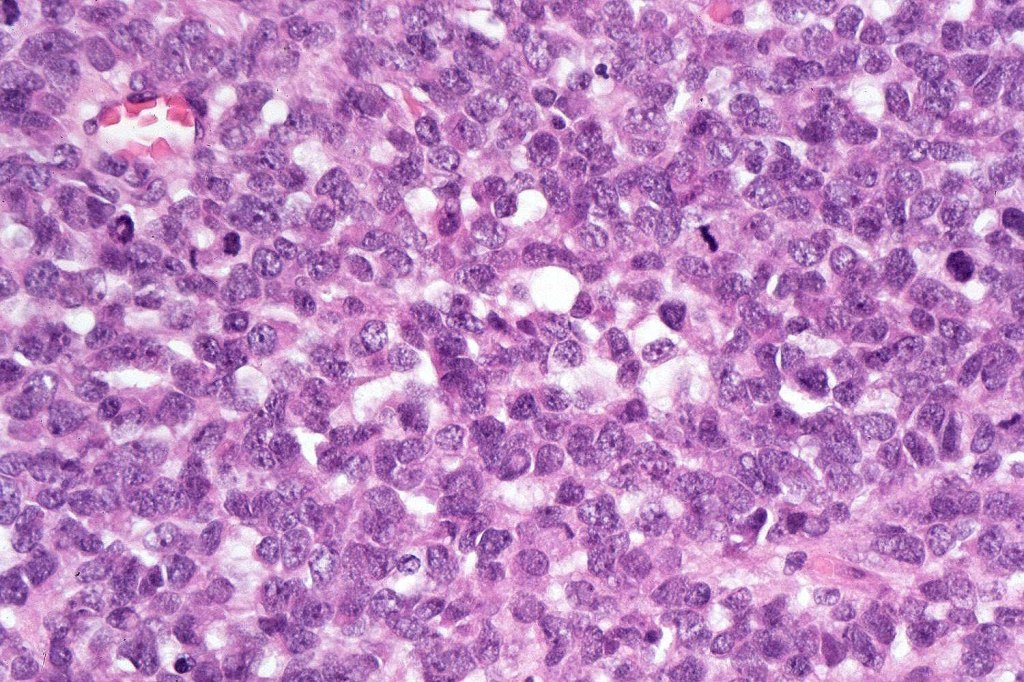
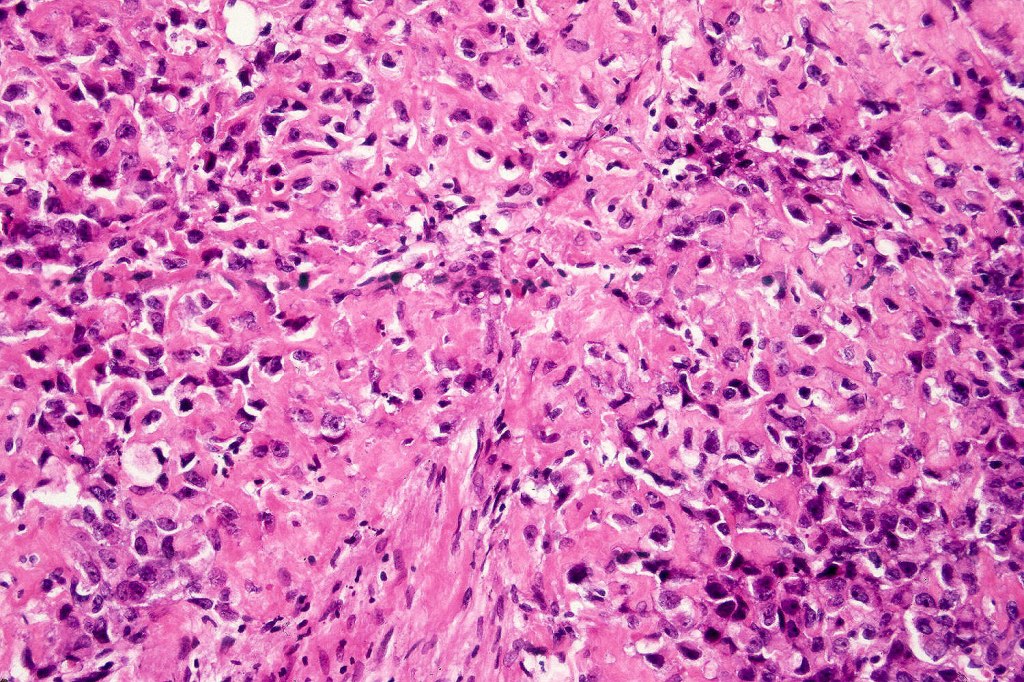
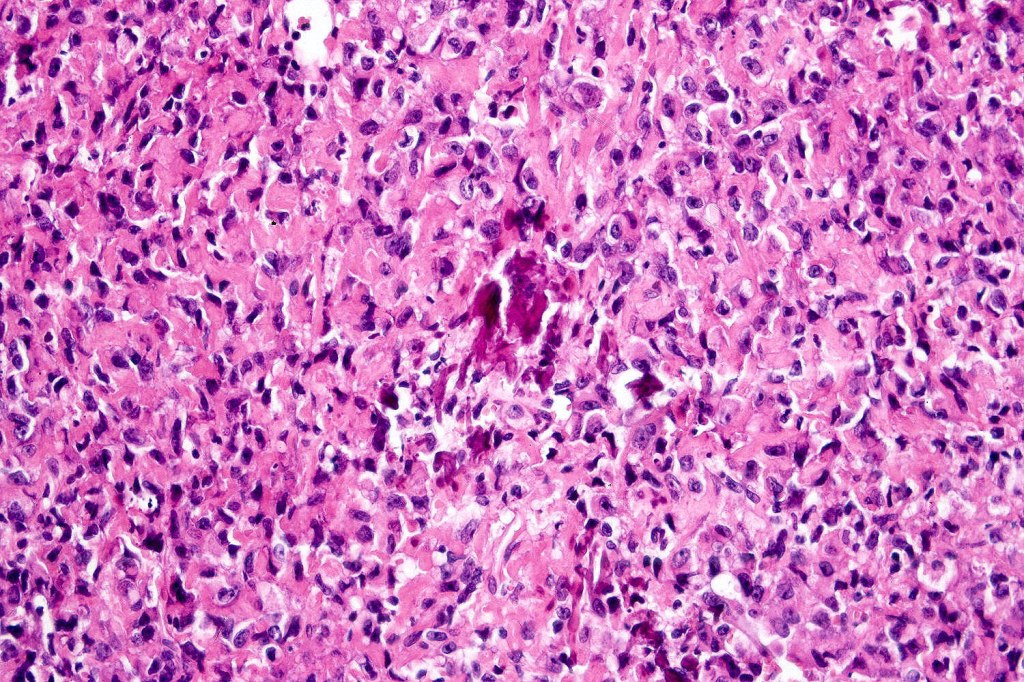
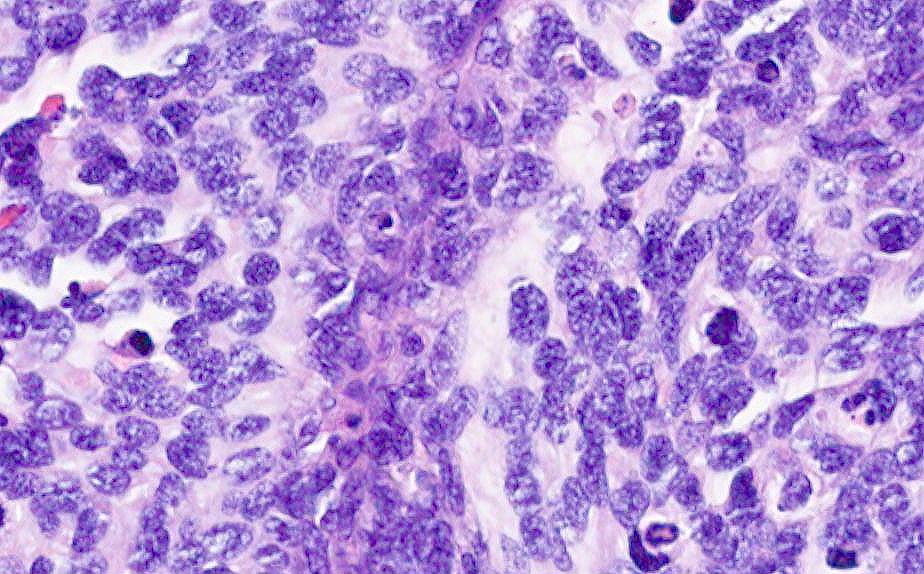

Melanoma with osteoid and chondroid (benign or malignant) are most often encountered in the digits particularly the thumb and large toe, for the other types, they are too rare to make any meaningful clinical comments. Documented heterologous elements include:
•Osteoid
•Chondroid
•Smooth muscle fibroblastic/myofibroblastic
•Rhabdomyosarcomatous
•Epithelial
•Schwannian
•Perineurial
•Ganglionic
•Ganglioneuroblastic
•Neuroendocrine
•Angiosarcomatous
. Epithelial

Leave a comment